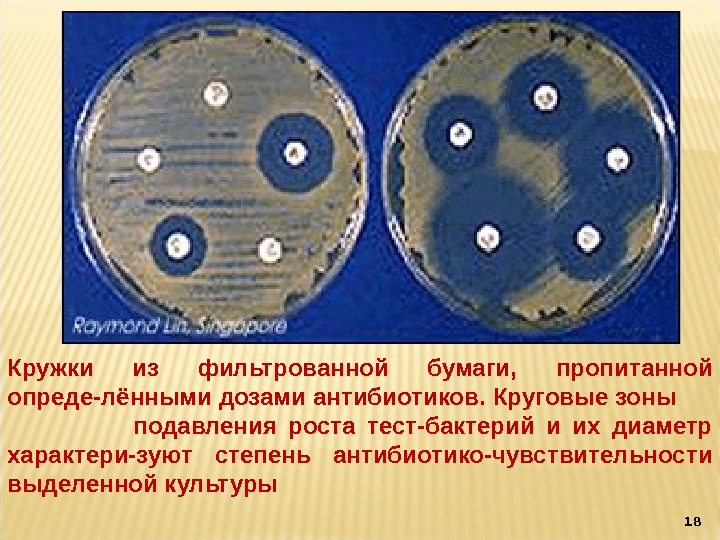

Зона задержки роста
Торговая площадка музыки
Факторы товарных запасов
Ростов на дону указатель
Загадка что приходит не уходя
Сапфир московская
Жизнь глента
Ущерб с франшизой
Домкрат подкатной сибртех отзывы
Ем белый мел
Комсомольское ш 3
Слушать рамазановлар
Выделения после мочеиспускания у мужчин причины
Хронология событий тест
Зона задержки роста 79 фото